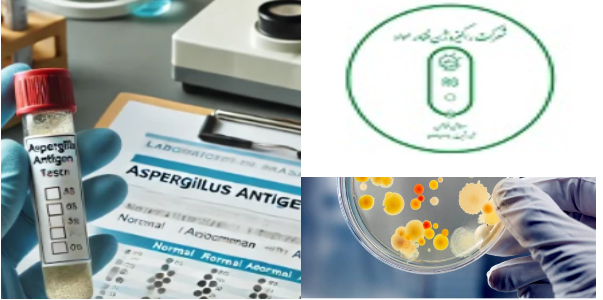
شرکت راکیزه ژن فناور مواد

واحدهای فناوری

امکان دسترسی به پایگاه داده های تخصصی برای شرکتهای مستقر در مرکز نوآوری سلولهای بنیادی و پزشکی بازساختی

انتصاب دکتر امیرعلی حمیدیه بهعنوان مشاور رئیس و دبیر کمیته نوآوری و شتابدهی جمت هلالاحمر

برگزاری سومین نشست شورای مرکز نوآوری سلولهای بنیادی و پزشکی بازساختی

برگزاری جلسه با شرکت لیداکس

موفقیت جدید در حوزه فناوری و نوآوری در دانشگاه علوم پزشکی تهران

برگزاری دومین نشست شورای مرکز نوآوری سلولهای بنیادی و پزشکی بازساختی

فراخوان ارائه طرحهای فناورانه در حوزه سلامت

برگزاری اولین نشست شورای مرکز نوآوری سلولهای بنیادی و پزشکی بازساختی دانشگاه علوم پزشکی تهران
.jpg)
کسب مقام دوم رویداد بزرگ کنسر بایوتلنت توسط شرکت بهنیا زیست فناور از واحدهای فناور مستقر در مرکز سلولهای بنیادی و پزشکی بازساختی

تفاهمنامه همکاری میان دانشکده پزشکی دانشگاه علوم پزشکی تهران و گروه دارویی کوبل امضا شد

معرفی ظرفیتهای فناورانه در مرکز رشد فناوری سلامت دانشگاه علوم پزشکی تهران

حضور شرکت بهنیا زیست فناور در رویداد بایوتلنت

_crop.jpg)
















